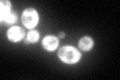
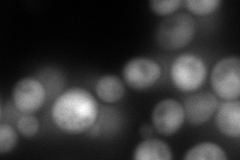
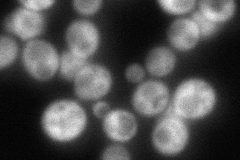
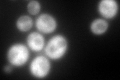
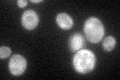

View description
Positive regulator of the Gcn2p kinase activity, forms a complex with Gcn1p; proposed to stimulate Gcn2p activation by an uncharged tRNA
Localization:
Intensity:
Fold change:
Significance:
-
C’ GFP library in SD
cytosol137.14 -
N' NOP1pr-GFP in SD

cytosol180.932 -
N' TEF2pr-mCherry in SD
cytosol228.386 -
N' NATIVEpr-GFP in SD
cytosol125.12 -
N' TEF2pr-VC and Cyto-VN in SD

cytosol64.4923 -
C’ GFP library in SD+DTT
cytosol150.091.09No -
C’ GFP library in SD+H2O2

cytosol144.221.05No -
C’ GFP library in Starvation Media
cytosol87.720.63No -
C’ GFP library on the background of Pup2-DaMP

cytosol -
C’ GFP library on the background of CCT mutant

cytosol162.3491.1837No
